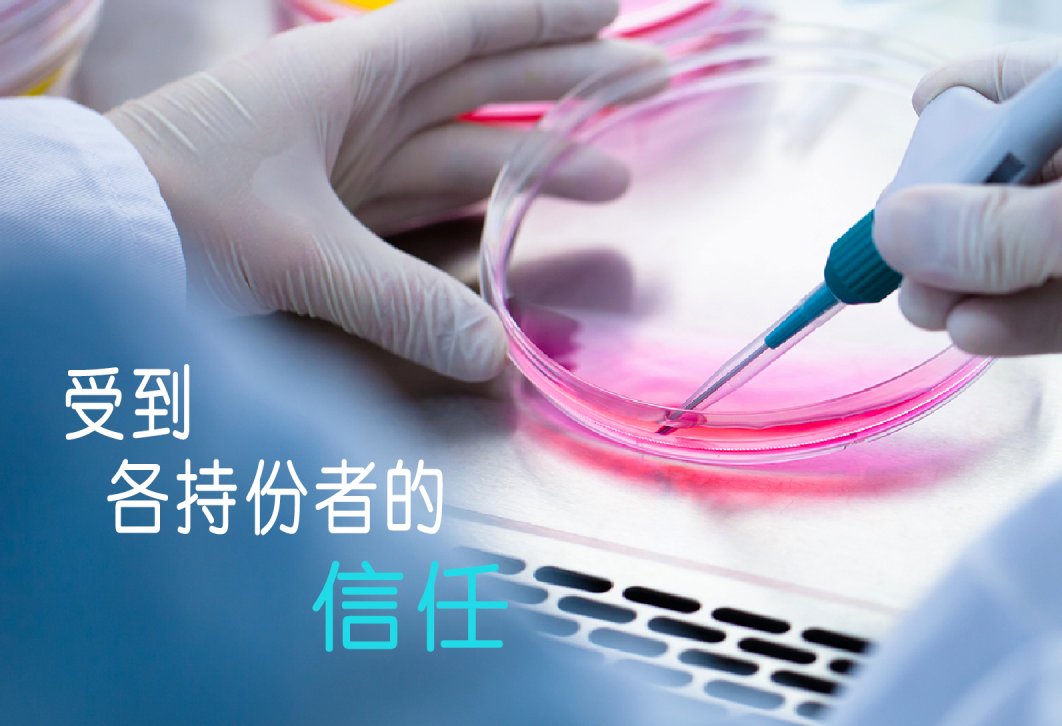

滾動


關於我們
利斯集團(LSB)成立於2003年,多年來穏步發展並成為行業中主要藥品供應商之一。我們代表全球多間知名的主要製造商,業務包括採購、註冊、產品設計、市場策劃和營銷等。 利斯集團秉承「我們提供更多選擇」的使命,成為行業中具影響力及可信賴的企業,向社會提供高質量、價格合理的藥物及健康護理用品,並為所有持份者創造價值。
為配合集團發展需要及公司重組,利斯(香港)有限公司(利斯香港)的全資子公司利思醫藥有限公司(利思醫藥)於2018年成立。
二零一九年四月一日開始,利思醫藥負責集團的健康護理業務,所有銷售及市場推廣亦由利思醫藥執行。
利思醫藥將呈現更多元化的產品組合,並提升服務及管理質素。同時,利斯香港會繼續運作,為利思醫藥的控股公司。
閱讀更多